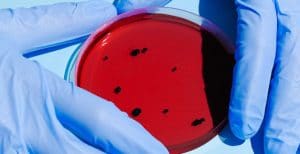
Tarihte ilk olarak 1958’de maymunda bulunan virüs, insanlar arasında ilk

Ana Sayfa
Arama
 Nöbetçi Eczaneler
Hava Durumu
Namaz Vakitleri
Puan Durumu
Nöbetçi Eczaneler
Hava Durumu
Namaz Vakitleri
Puan Durumu
Kategoriler
Servisler
WhatsApp
Sosyal Medya